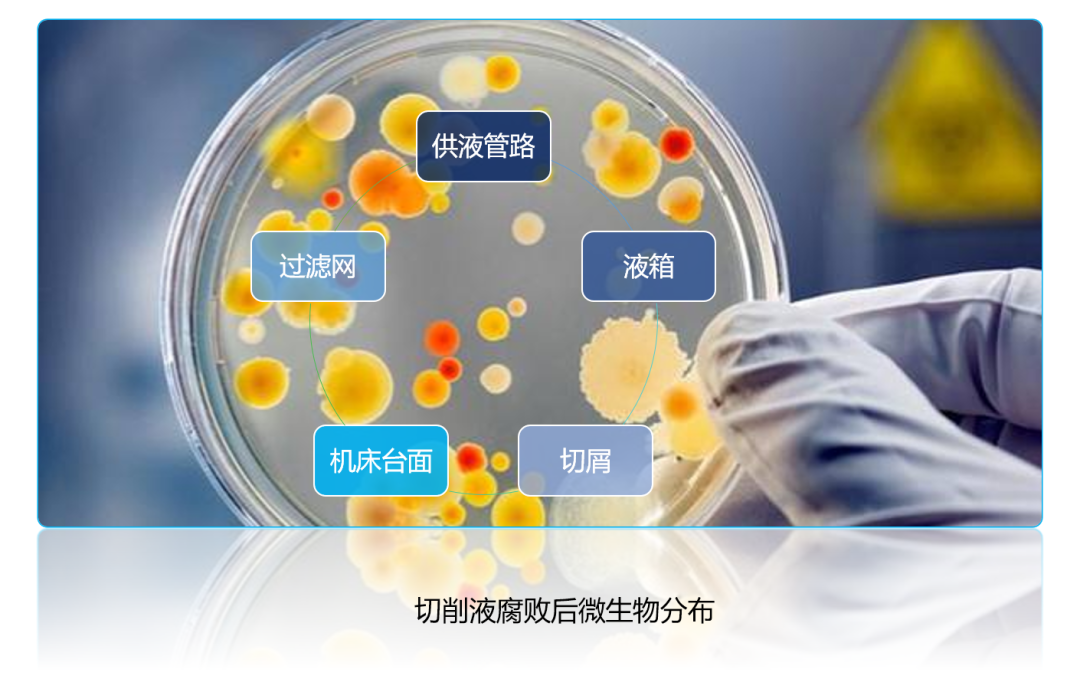

金属加工液生菌的主要表现为发生腐败,其过程依次为:轻微腐臭→外观变灰褐色→pH值不断下降→防锈性变坏→乳化液破乳分层,出现浮油→切削性能下降→大量油泥形成,过滤设备堵塞→释放硫化氢气体,车间空气恶化。
那么,面对出现不同问题状况的金属加工液,企业又该如何应对呢?
“
轻症选“治疗”
如果检测菌落数值达到细菌103CFU/ml,霉菌101CFU/ml以上,则可判断槽液为生菌状态,此时企业需引起关注并进行及时调整。
Problem Resolution
“
重症选“换槽”
如果检测菌落数值达到细菌105CFU/ml,霉菌103CFU/ml以上,则建议企业对槽液进行换槽,同时考虑到机床管路等隐蔽的角落会残留细菌,因此企业在换槽时应充分清洗去除菌落。否则,换槽后的新鲜切削液也会被其中的菌落在极短时间内繁殖非常高的数量级,导致金属加工液将面临再次腐败。
因此,正确的换槽步骤为:彻底清理槽液——清除液箱侧面及底部的切屑、菌皮——低浓度金属加工液加杀菌剂充分清洗、排净——配液使用。
此处值得一提的是,人工清理加工机床槽液中细小的切屑、磨灰耗时费力。若改用快速换槽设备,则可大大提高工作效率,改善工人工作体验。以科润分体式槽液快速清理机KR-ETC300B为例,该设备具有冲洗彻底,安全环保,操作便捷,清理高效的特点,可满足每分钟吸液200L,排液速度2000L/H,可实现边抽液边排液同时进行。此外,设备标配臭氧杀菌功能,可有效帮助企业做好机床金属加工液的清槽/倒槽的维护保养工作,让流体保养工作变得轻松便捷!

图 | 科润液槽快速清理机KR-ETC300B


图 | 改善现场客观环境(杂油、油泥等)
“
想要不生菌?往下看↓↓↓
夏季,金属加工液生菌的高发季节。小科温馨提示:务必通过 ① 精准管理pH值;② 重视控制浓度;③ 创建整洁工作环境等手段做好预防工作!
如果遇到停机情况,记得做好定期循环,避免金属加工液长时间处于无氧状态。如果是短时间停机,可在停机前将浓度提升2-3%;如果是长时间停机,则建议将槽液抽到别的机床进行使用。
科润,致力于成为绿色工业介质的领航者,用流动的科技,助高端智造远航。
